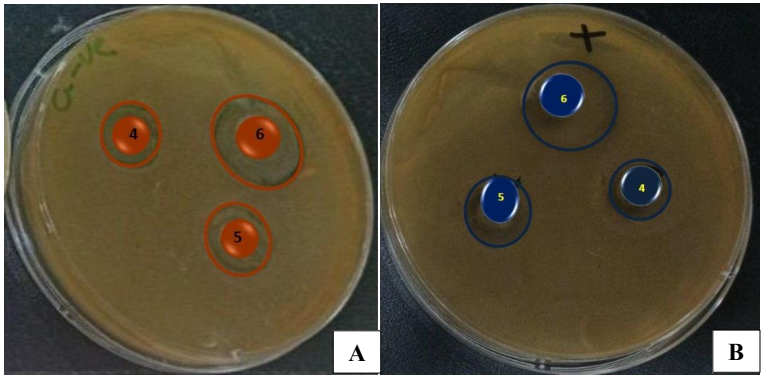

-
生物通官微
陪你抓住生命科技
跳动的脉搏
银/氧化铜纳米复合材料的合成、表征及其对革兰氏阴性菌的协同抗菌效应研究
【字体: 大 中 小 】 时间:2025年07月08日 来源:Oxford Open Materials Science 2.9
编辑推荐:
本研究针对抗生素耐药性全球危机,通过化学还原-超声复合技术制备Ag/CuO纳米复合材料,解决了传统抗菌剂效率低、成本高的问题。团队采用SEM、XRD、FTIR等技术表征材料特性,证实其具有43.84 nm均匀粒径和FCC晶相结构。抗菌实验显示该复合材料对E.coli(抑菌圈18 mm)的活性显著优于单一组分(Ag 15 mm,CuO 12 mm),为新型抗菌剂开发提供新思路。论文发表于《Oxford Open Materials Science》。
研究背景与意义
抗生素耐药性已成为全球公共卫生领域的"定时炸弹",世界卫生组织数据显示2019年相关死亡人数高达495万。传统抗生素开发陷入瓶颈之际,纳米材料因其独特的物理化学性质成为对抗"超级细菌"的新希望。其中,银纳米颗粒(AgNPs)和氧化铜(CuO)纳米颗粒分别以膜破坏和活性氧(ROS)生成机制著称,但单一材料存在成本高或效率低的局限。巴比伦大学与Al Mustaqbal大学的研究团队创新性地将两者复合,通过结构优化实现协同抗菌,相关成果发表于《Oxford Open Materials Science》。
关键技术方法
研究采用三步法制备材料:1)葡萄糖还原法合成AgNPs;2)碱沉淀法制备CuO NPs;3)超声辅助负载构建Ag/CuO复合材料。通过SEM观测形貌,XRD分析晶相,FTIR检测官能团,EDX验证元素组成。抗菌实验采用琼脂扩散法,测试菌株为临床分离的E.coli(ATCC25922)和S.aureus(ATCC25923),通过抑菌圈直径评估效果。
研究结果
3.1 仪器分析
SEM显示AgNPs存在25.8 nm团聚现象,CuO呈35.92 nm均匀球形,复合后粒径增至43.84 nm。


3.2 抗菌活性
琼脂扩散实验表明:Ag/CuO对E.coli抑菌圈达18 mm,显著优于单独Ag(15 mm)和CuO(12 mm)。
结论与展望
该研究通过超声辅助复合技术成功构建Ag/CuO纳米材料,其抗菌效率较文献报道的绿色合成法提高20%(Mosleh et al., 2024),且粒径更均匀。协同效应可能源于:1)Ag+与Cu2+离子双重攻击;2)增强的ROS生成;3)优化后的界面接触面积。这种成本仅为纯银材料1/3的复合材料,为临床抗感染治疗提供了新选择,未来可进一步探索其在医疗器械涂层中的应用潜力。
生物通微信公众号
知名企业招聘